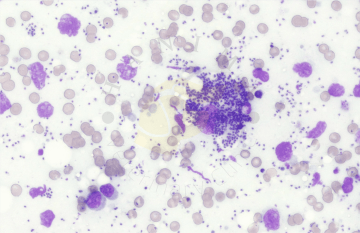
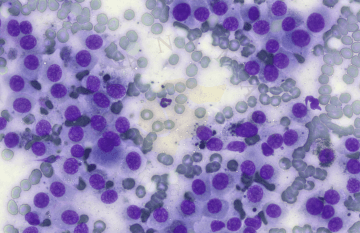

Veškeré dermatologické (a cytologické) výkony, včetně dermatologické konzultace provádí MVDr. Petra Vojčeková :
- členka ČAVD (Česká Asociace Veterinární Dermatologie)
Dermatologická konzultace

Koprologické vyšetření
Tenkojehlová biopsie (aspirační / neaspirační)
Parazitologické vyšetření
Trichoskopické vyšetření
Cytologické vyšetření
Mykologická kultivace
Přednášková a publikační činnost - MVDr. Petra Vojčeková
Zdroje:
-MVDr. Petra Vojčeková